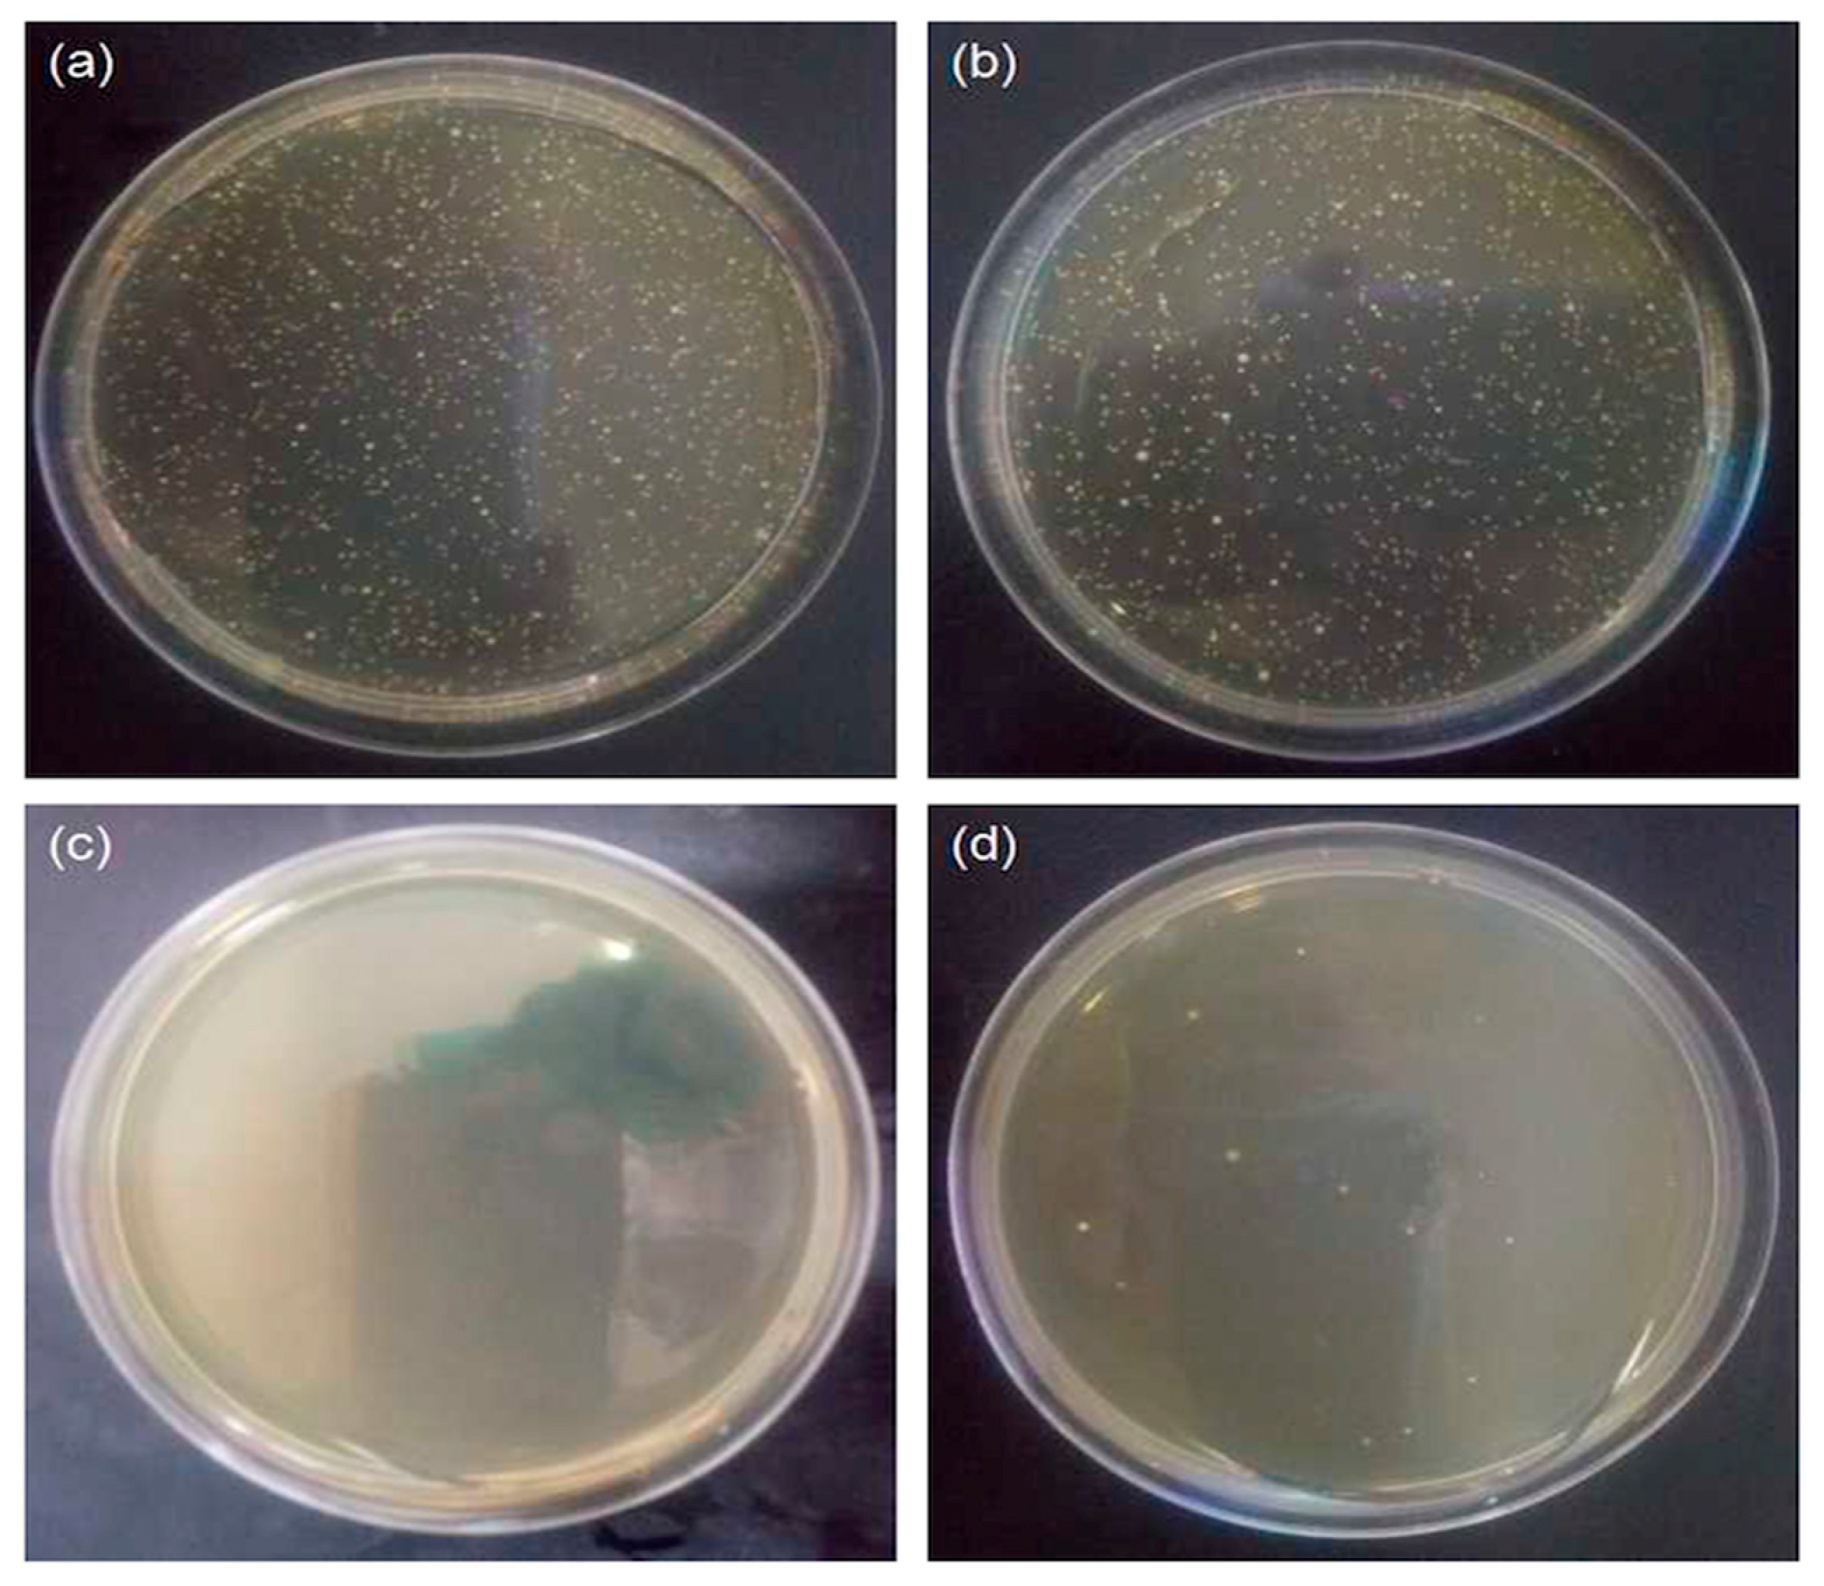
Polymers 10 00495 g009

Growing ZnO Nanoparticles on Polydopamine-Templated Cotton Fabrics for Durable Antimicrobial Activity and UV Protection
Abstract
:1. Introduction
2. Experimental
2.1. Materials
2.2. Preparation of ZnO-Coated Cotton Fabrics
2.3. Characterizations and Measurements
3. Results and Discussion
3.1. Mechanism
3.2. Characterizations
3.2.1. Morphology
3.2.2. EDX Analysis
3.2.3. XPS Analysis
3.2.4. Crystalline Structure
3.2.5. UV–Vis Spectrophotometry
3.2.6. Thermogravimetric Analysis
3.3. Functions
3.3.1. UV Protection
3.3.2. Antibacterial Activity
4. Conclusions
Author Contributions
Funding
Conflicts of Interest
References
- Yetisen, A.K.; Qu, H.; Manbachi, A.; Butt, H.; Dokmeci, M.R.; Hinestroza, J.P. Nanotechnology in Textiles. ACS Nano 2016, 10, 3042–3068. [Google Scholar] [CrossRef] [PubMed]
- Moiz, A.; Padhye, R.; Wang, X. Coating of TPU-PDMS-TMS on polycotton fabrics for versatile protection. Polymers 2017, 9, 660. [Google Scholar] [CrossRef]
- Caschera, D.; Mezzi, A.; Cerri, L. Effects of plasma treatments for improving extreme wettability behavior of cotton fabrics. Cellulose 2014, 21, 741–756. [Google Scholar] [CrossRef]
- Abidi, N.; Cabrales, L.; Hequet, E. Functionalization of a cotton fabric surface with titania nanosols: Applications for self-cleaning and UV-protection properties. ACS Appl. Mater. Interfaces 2009, 1, 2141–2146. [Google Scholar] [CrossRef] [PubMed]
- Liu, H.; Lv, M.; Deng, B. Laundering durable antibacterial cotton fabrics grafted with pomegranate-shaped polymer wrapped in silver nanoparticle aggregations. Sci. Rep. 2014, 4, 5920–5929. [Google Scholar] [CrossRef] [PubMed]
- Ates, E.S.; Unalan, H.E. Zinc oxide nanowire enhanced multifunctional coatings for cotton fabrics. Thin Solid Films 2012, 520, 4658–4661. [Google Scholar] [CrossRef]
- Selvam, S.; Sundrarajan, M. Functionalization of cotton fabric with PVP/ZnO nanoparticles for improved reactive dyeability and antibacterial activity. Carbohyd. Polym. 2012, 87, 1419–1424. [Google Scholar] [CrossRef]
- Wang, C.; Lv, J.; Ren, Y. Cotton fabric with plasma pretreatment and ZnO/Carboxymethyl chitosan composite finishing for durable UV resistance and antibacterial property. Carbohyd. Polym. 2016, 138, 106–113. [Google Scholar] [CrossRef] [PubMed]
- Manna, J.; Goswami, S.; Shilpa, N. Biomimetic Method to Assemble Nanostructured Ag@ZnO on Cotton Fabrics: Application as Self-cleaning Flexible Materials with Visible-light Photocatalysis and Antibacterial Activities. ACS Appl. Mater. Interfaces 2015, 7, 8076–8082. [Google Scholar] [CrossRef] [PubMed]
- Xu, L.; Zhuang, W.; Xu, B. Fabrication of superhydrophobic cotton fabrics by silica hydrosol and hydrophobization. Appl. Surf. Sci. 2011, 257, 5491–5498. [Google Scholar] [CrossRef]
- Shaban, M.; Mohamed, F.; Abdallah, S. Production and Characterization of Superhydrophobic and Antibacterial Coated Fabrics Utilizing ZnO Nanocatalyst. Sci. Rep. 2018, 8, 3925–3940. [Google Scholar] [CrossRef] [PubMed]
- Svetlichnyi, V.; Shabalina, A.; Lapin, I. ZnO nanoparticles obtained by pulsed laser ablation and their composite with cotton fabric: Preparation and study of antibacterial activity. Appl. Surf. Sci. 2016, 372, 20–29. [Google Scholar] [CrossRef]
- Perelshtein, I.; Applerot, G.; Perkas, N. Antibacterial Properties of an In Situ Generated and Simultaneously Deposited Nanocrystalline ZnO on Fabrics. ACS Appl. Mater. Interfaces 2009, 1, 361–366. [Google Scholar] [CrossRef] [PubMed]
- Uğur, Ş.S.; Merih, S.; Hakan, A.A. Modifying of Cotton Fabric Surface with Nano-ZnO Multilayer Films by Layer-by-Layer Deposition Method. Nanoscale Res. Lett. 2010, 5, 1204–1210. [Google Scholar] [CrossRef] [PubMed]
- Preda, N.; Enculescu, M.; Zgura, I. Superhydrophobic properties of cotton fabrics functionalized with ZnO by electroless deposition. Mater. Chem. Phys. 2013, 138, 253–261. [Google Scholar] [CrossRef]
- Xu, B.; Cai, Z. Fabrication of a superhydrophobic ZnO nanorod array film on cotton fabrics via a wet chemical route and hydrophobic modification. Appl. Surf. Sci. 2008, 254, 5899–5904. [Google Scholar] [CrossRef]
- Sadanarn, V.; Tian, H.; Rajulu, A.V.; Satyanarayana, B. Antibacterial cotton fabric with in situ generated silver nanoparticles by one-step hydrothermal method. Int. J. Polym. Anal. Charact. 2017, 22, 275–279. [Google Scholar]
- Sadnarn, V.; Feng, T.H.; Rajulu, A.V.; Satyanarayana, B. Preparation and properties of low-cost cotton nanocomposite fabrics with in situ-generated copper nanoparticles by simple hydrothermal method. Int. J. Polym. Anal. Charact. 2017, 22, 587–594. [Google Scholar]
- Manna, J.; Begum, G.; Kumar, K.P. Enabling antibacterial coating via bioinspired mineralization of nanostructured ZnO on fabrics under mild conditions. ACS Appl. Mater. Interfaces 2013, 5, 4457–4463. [Google Scholar] [CrossRef] [PubMed]
- Thakur, V.K.; Vennerberg, D.; Kessler, M.R. Green aqueous surface modification of polypropylene for novel polymer nanocomposites. ACS Appl. Mater. Interfaces 2014, 6, 9349–9456. [Google Scholar] [CrossRef] [PubMed]
- Thakur, V.K.; Vennerberg, D.; Madbouly, S.A.; Kessler, M.R. Bio-inspired green surface functionalization of PMMA for multifunctional capacitors. RSC Adv. 2014, 4, 6677–6684. [Google Scholar] [CrossRef]
- Trache, D.; Hussin, M.H.; Haafiz, M.K.M.; Thakur, V.K. Recent progress in cellulose nanocrystals: Sources and production. Nanoscale 2017, 9, 1763–1786. [Google Scholar] [CrossRef] [PubMed]
- Lee, H.; Dellatore, S.M.; Miller, W.M. Mussel-inspired surface chemistry for multifunctional coatings. Science 2007, 318, 426–430. [Google Scholar] [CrossRef] [PubMed]
- Ingole, P.G.; Choi, W.; Kim, K.H. Synthesis, characterization and surface modification of PES hollow fiber membrane support with polydopamine and thin film composite for energy generation. Chem. Eng. J. 2014, 243, 137–146. [Google Scholar] [CrossRef]
- Li, B.; Lei, W.; Li, L. Superwetting Double-Layer Polyester Materials for Effective Removal of Both Insoluble Oils and Soluble Dyes in Water. ACS Appl. Mater. Interfaces 2014, 6, 11581–11588. [Google Scholar] [CrossRef] [PubMed]
- Hu, H.W.; Xin, J.H.; Hu, H. Highly Efficient Graphene-Based Ternary Composite Catalyst with Polydopamine Layer and Copper Nanoparticles. Chempluschem 2013, 78, 1483–1490. [Google Scholar] [CrossRef]
- Guo, F.; Wen, Q.; Peng, Y. Simple one-pot approach toward robust and boiling-water resistant superhydrophobic cotton fabric and the application in oil/water separation. J. Mater. Chem. A 2017, 5, 21866–21874. [Google Scholar] [CrossRef]
- Fu, S.; Zhou, H.; Wang, H. Magnet-responsive, superhydrophobic fabrics from waterborne, fluoride-free coatings. RSC Adv. 2018, 8, 717–723. [Google Scholar] [CrossRef]
- Cheng, D.; He, M.; Ran, J.; Wang, X. In situ reduction of TiO2 nanoparticles on cotton fabrics through polydopamine templates for photocatalysis and UV protection. Cellulose 2018, 25, 1413–1424. [Google Scholar] [CrossRef]
- Athauda, T.J.; Ozer, R.R. Nylon Fibers as Template for the Controlled Growth of Highly Oriented Single Crystalline ZnO Nanowires. Cryst. Growth Des. 2013, 13, 2680–2686. [Google Scholar] [CrossRef]
- Athauda, T.J.; Hari, P.; Ozer, R.R. Tuning Physical and Optical Properties of ZnO Nanowire Arrays Grown on Cotton Fibers. ACS Appl. Mater. Interfaces 2013, 5, 6237–6246. [Google Scholar] [CrossRef] [PubMed]
- Tian, Y.; Cao, Y.; Wang, Y. Realizing Ultrahigh Modulus and High Strength of Macroscopic Graphene Oxide Papers Through Crosslinking of Mussel-Inspired Polymers. Adv. Mater. 2013, 25, 2980–2983. [Google Scholar] [CrossRef] [PubMed]
- Shinde, S.S.; Shinde, P.S.; Oh, Y.W. Investigation of structural, optical and luminescent properties of sprayed N-doped zinc oxide thin films. J. Anal. Appl. Pyrol. 2012, 97, 181–188. [Google Scholar] [CrossRef]
- Jiao, L.; Ma, J.; Dai, H. Preparation and Characterization of Self-Reinforced Antibacterial and Oil-Resistant Paper Using a NaOH/Urea/ZnO Solution. PLoS ONE 2015, 10, 179–183. [Google Scholar] [CrossRef] [PubMed]
- Sun, X.Z.; Bremner, D.H.; Wan, N. Development of antibacterial ZnO-loaded cotton fabric based on in situ fabrication. Appl. Phys. A 2016, 122, 940–949. [Google Scholar] [CrossRef]
- Bernsmann, F.; Frisch, B.; Ringwald, C.; Ball, V. Protein adsorption on dopamine-melanin films: Role of electrostatic interactions inferred from zeta-potential measurements versus chemisorption. J. Colloid Interf. Sci. 2010, 344, 54–60. [Google Scholar] [CrossRef] [PubMed]
- Jazbec, K.; Sala, M.; Mozetic, M.; Vesel, A.; Gorjanc, M. Functionalization of cellulose fibres with oxygen plasma and ZnO nanoparticles for achieving UV protective properties. J. Nanomater. 2015, 2015, 346739. [Google Scholar] [CrossRef]
- Shateri-Khalilabad, M.; Yazdanshenas, M.E. Bifunctionalization of cotton textiles by ZnO nanostructures: Antimicrobial activity and ultraviolet protection. Text. Res. J. 2013, 83, 993–1004. [Google Scholar] [CrossRef]
- Pandimurugan, R.; Thambidurai, S. UV protection and antibacterial properties of seaweed capped ZnO nanoparticles coated cotton fabrics. Int. J. Biol. Macromol. 2017, 105, 788–795. [Google Scholar] [CrossRef] [PubMed]
- Ghayempour, S.; Montazer, M. Ultrasound irradiation based in-situ synthesis of star-like Tragacanth gum/zinc oxide nanoparticles on cotton fabric. Ultrason. Sonochem. 2017, 34, 458–465. [Google Scholar] [CrossRef] [PubMed]

| Samples | UPF | T (UVA) (%) | T (UVB) (%) | UPF Rating |
|---|---|---|---|---|
| Pristine cotton fabrics | 6.4 | 10.68 | 8.45 | poor |
| PDA-templated cotton fabrics | 36.8 | 2.1 | 1.6 | good |
| ZnO-coated cotton fabrics | 157.8 | 0.46 | 0.31 | excellent |
© 2018 by the authors. Licensee MDPI, Basel, Switzerland. This article is an open access article distributed under the terms and conditions of the Creative Commons Attribution (CC BY) license (http://creativecommons.org/licenses/by/4.0/).
Share and Cite
Ran, J.; He, M.; Li, W.; Cheng, D.; Wang, X. Growing ZnO Nanoparticles on Polydopamine-Templated Cotton Fabrics for Durable Antimicrobial Activity and UV Protection. Polymers 2018, 10, 495. https://doi.org/10.3390/polym10050495
Ran J, He M, Li W, Cheng D, Wang X. Growing ZnO Nanoparticles on Polydopamine-Templated Cotton Fabrics for Durable Antimicrobial Activity and UV Protection. Polymers. 2018; 10(5):495. https://doi.org/10.3390/polym10050495
Chicago/Turabian StyleRan, Jianhua, Mantang He, Wenbin Li, Deshan Cheng, and Xin Wang. 2018. "Growing ZnO Nanoparticles on Polydopamine-Templated Cotton Fabrics for Durable Antimicrobial Activity and UV Protection" Polymers 10, no. 5: 495. https://doi.org/10.3390/polym10050495
APA StyleRan, J., He, M., Li, W., Cheng, D., & Wang, X. (2018). Growing ZnO Nanoparticles on Polydopamine-Templated Cotton Fabrics for Durable Antimicrobial Activity and UV Protection. Polymers, 10(5), 495. https://doi.org/10.3390/polym10050495

